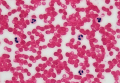
Гемофилия small

Лекарственные препараты в справочнике Веленси
В мета-анализе индивидуальных данных 123 940 участников исследований большинство нежелательных явлений из инструкций к статинам не подтвердилось
Хроническая обструктивная болезнь легких (ХОБЛ) – это прогрессирующее заболевание, которое необратимо повреждает легкие и является третьей ведущей причиной смерти в мире
На протяжении 35-летней истории «Эвалар» ведет масштабную исследовательскую работу с ведущими научно-клиническими центрами. Особо тесное сотрудничество установилось с урологами и андрологами: компания выпускает востребованные препараты для поддержки здоровья мочевыводящих путей
Тяжёлое и длительное употребление алкоголя связано с более высоким риском колоректального рака, особенно рака прямой кишки
 Аневризма – это патологическое состояние, при котором истонченная, ослабленная стенка сосуда выпячивается, сосуд расширяется и создает давление на прилегающие ткани
Аневризма – это патологическое состояние, при котором истонченная, ослабленная стенка сосуда выпячивается, сосуд расширяется и создает давление на прилегающие ткани
 Тератома – это герминогенная опухоль (киста), образующаяся из клеток зародышевых листков, то есть слоев тела зародыша
Тератома – это герминогенная опухоль (киста), образующаяся из клеток зародышевых листков, то есть слоев тела зародыша
Гемофилия – это наследственное заболевание, при котором из-за нарушения процессов свертывания крови даже небольшое повреждение кожи или ушиб может привести к серьезному кровотечению
Гемофилия – это наследственное заболевание, при котором из-за нарушения процессов свертывания крови даже небольшое повреждение кожи или ушиб может привести к серьезному кровотечению
 Сонный паралич – это состояние, когда во время сна, чаще при засыпании или пробуждении, человек не может управлять своими мышцами
Сонный паралич – это состояние, когда во время сна, чаще при засыпании или пробуждении, человек не может управлять своими мышцами
 Лудомания – это зависимость, когда влечение к компьютерным или азартным играм становится доминирующим в жизни человека, вытесняет другие интересы
Лудомания – это зависимость, когда влечение к компьютерным или азартным играм становится доминирующим в жизни человека, вытесняет другие интересы
 Стрептодермия – это гнойное заболевание кожи, которое вызывается стрептококками, чаще группы А
Стрептодермия – это гнойное заболевание кожи, которое вызывается стрептококками, чаще группы А
 Дислексия – это особенность работы мозга, при которой человеку при нормальном интеллекте и зрении сложно идентифицировать буквы
Дислексия – это особенность работы мозга, при которой человеку при нормальном интеллекте и зрении сложно идентифицировать буквы
 Гетерохромия – это редкое состояние (не заболевание), при котором у человека глаза разного цвета либо в радужной оболочке одного глаза два или более оттенков
Гетерохромия – это редкое состояние (не заболевание), при котором у человека глаза разного цвета либо в радужной оболочке одного глаза два или более оттенков
 Сегодня речь пойдет о группе внутриклеточных бактерий, вызывающих множество проблем в практическом здравоохранении, а именно о хламидиях. И начнем с понимания, кто есть кто, то есть с классификации, которая очень важна для дальнейшего понимания, что и как делать с пациентом.
Сегодня речь пойдет о группе внутриклеточных бактерий, вызывающих множество проблем в практическом здравоохранении, а именно о хламидиях. И начнем с понимания, кто есть кто, то есть с классификации, которая очень важна для дальнейшего понимания, что и как делать с пациентом.
 Ввиду наступления очередного сезона простудных заболеваний самое время поговорить о сегодняшней нашей героине.
Ввиду наступления очередного сезона простудных заболеваний самое время поговорить о сегодняшней нашей героине.






